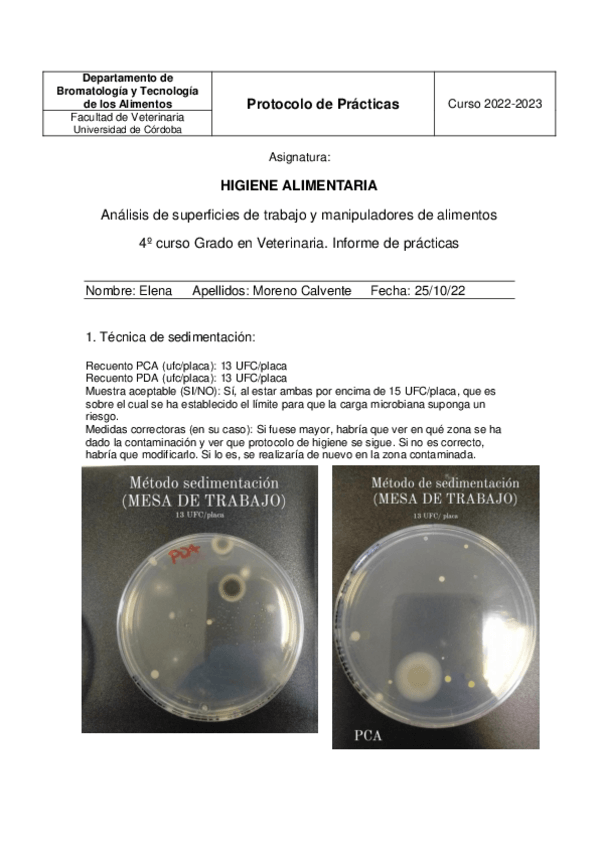
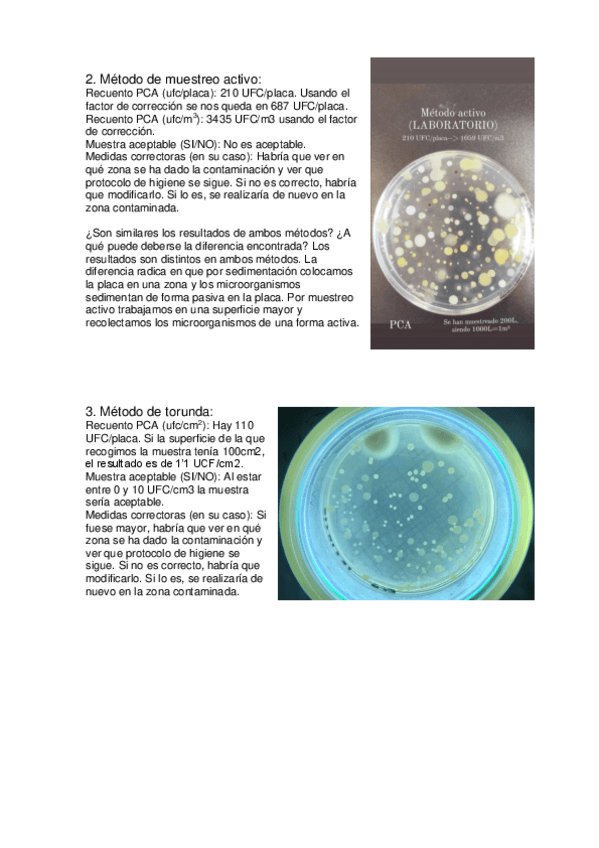

@RemusLupin
181 Publicaciones
2.92k Interacciones
6 Seguidores
0 Siguiendo
Lista de publicaciones de RemusLupin
He publicado nuevos apuntes de 5º Economía de la Producción Ganadera: Problemas-de-las-Diapositivas.pdf
He publicado nuevos apuntes de 4º Anestesiología y Cuidados Intensivos: FARMACOS-ANESTESIOLOGIA.pdf
He publicado nuevos apuntes de 4º Anestesiología y Cuidados Intensivos: Proceso-Anestesico-RESUMEN.pdf
He publicado nuevos apuntes de 3º Enfermedades Parasitarias: Tabla-Primer-Parcial-COCCIDIOS.pdf
apuntes
-
Segundo parcial resumido
Descripción de las fotos de clase y práctica esquematizadas y completas. Se añade todo lo que hay que poner en el exámen y las clasificaciones.
He publicado nuevos examenes de 4º Inspección y Control Alimentario: RECOPILACION-PREGUNTAS-LARGAS-Y-TEST-LECHE.pdf
He publicado nuevos apuntes de 1º Etnología, Etología y Bienestar Animal: ETOGRAMA.pdf
He publicado nuevos apuntes de 4º Inspección y Control Alimentario: Informe-laboratorio-practica-peces.pdf
He publicado nuevos apuntes de 4º Inspección y Control Alimentario: Informe-laboratorio-practica-leche.pdf
He publicado nuevos apuntes de 4º Inspección y Control Alimentario: Informe-laboratorio-practica-huevos.pdf
He publicado nuevos apuntes de 4º Inspección y Control Alimentario: Trabajo PNCOCA.pdf
He publicado nuevos apuntes de 4º Inspección y Control Alimentario: Pesca-sostenible.pdf
He publicado nuevos apuntes de 4º Inspección y Control Alimentario: Definicion-de-virus-y-bacterias.pdf
He publicado nuevos apuntes de 4º Inspección y Control Alimentario: Definicion-de-parasitos.pdf
He publicado nuevos apuntes de 4º Inspección y Control Alimentario: Definicion-de-conceptos.pdf
He publicado nuevos apuntes de 4º Higiene Alimentaria: Protocolo-practica-2-Elena-Moreno-Calvente8648ebdc27c94825841c09abdf9e3888.pdf
He publicado nuevos apuntes de 4º Higiene Alimentaria: Practica-1-de-Higiene.pdf
apuntes
-
Resúmenes apañados de APG
He publicado nuevos apuntes de 3º Anatomía Patológica Sistemática: Resúmenes apañados de APG